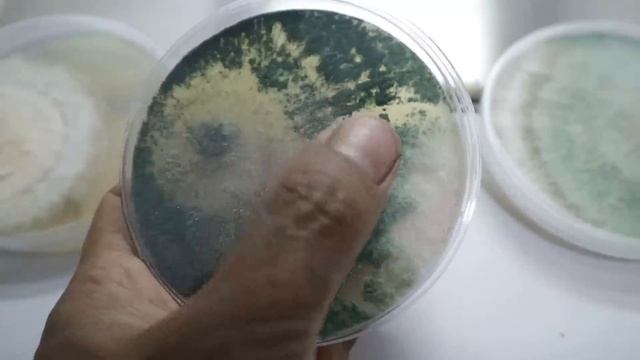
Atasi Penyakit Bercak Daun Pada Jahe Dengan Trichoderma | Uji In Vitro Lab Mini Lombok Organik смотреть онлайн

Автор / Канал: Лесная фантазия

"Ферма мобов" Супер русский skyblock № 9 прохождение карты

Ожерелье / Necklace

Принцы не спят. Крым. Сатера(1)

Foundational Supplements. Which ones are good for promoting wellness? Dr. Fredrickson explains

The Olive Oil Co Kitchen ~ S3 Ep.17 - Truffle Spring Omelette

В три строки 7 февраля 2019

Здоровые зубы/приятные новости/жизнь с рассеянным склерозом

Ролик о цифровой платформе для бурения ECO

Мы в лесу с 7 пацанами конец и опят не поладка

Читаю текст по Карма йоги ( йоги действия) с 28 по 32 пункт. Из Текстов Открытой Йоги.

Золотая Осень

Кришна (Комрат)

ЖК «Шенген» — Хід будівництва. Квітень-2022 | Корпорація Нерухомості РІЕЛ

Orange Cake Recipe / Orange Pound Cake / Tea time Orange Cake / Orange Chiffon Cake

Мухоморы | 🥇 | Испытания Фаиз | Genshin Impact 3.0

Для канала мистер бубл

RIZIN Open Weight GP 2016 Fan-Art Opening "Cage Is Your World"
Atasi Penyakit Bercak Daun Pada Jahe Dengan Trichoderma | Uji In Vitro Lab Mini Lombok Organik

Фунчоза с курицей МУКБАНГ mukbang

Brioche filled with sobrasada and honey with truffle

Пародия на клип (Тает лёд-Грибы)

❗Как выглядит плютей олений❗ #shorts #video #nature #fun #funny #грибы #лес #shortsvideo #short

Neobatrachia - Intro

сбш 250
За каждым успешным каналом стоит личность, идея и сотни часов кропотливого труда. Если вы здесь, значит, автор «Лесная фантазия» уже сумел зацепить ваше внимание своим уникальным стилем или подачей. А мы на RUVIDEO позаботились о том, чтобы вы могли изучить весь архив его работ в максимально комфортных условиях — без лишней суеты и преград.
Почему за работами канала «Лесная фантазия» так интересно наблюдать? Всё просто: это честный контент, который находит отклик в сердцах зрителей. На нашем ресурсе вы можете смотреть онлайн все видео любимого автора бесплатно и в хорошем качестве. Нам важно, чтобы вы видели каждую деталь и слышали каждый нюанс, поэтому мы используем только стабильные плееры из открытых источников Rutube.
Следите за новинками канала, пересматривайте старые шедевры и открывайте для себя новые грани творчества «Лесная фантазия». Мы постоянно обновляем ленту, чтобы у вас под рукой всегда были самые свежие выпуски. Никаких сложных регистраций — только вы и творчество, которое вдохновляет. Приятного вам путешествия по миру авторского контента на RUVIDEO!
Видео взято из открытых источников Rutube. Если вы правообладатель, обратитесь к первоисточнику.